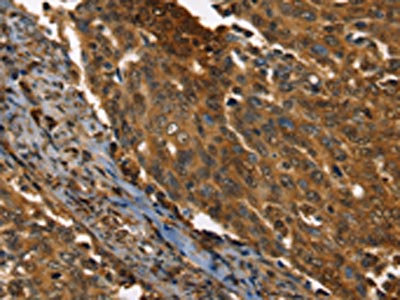

PPIA Antibody
-
中文名稱:PPIA兔多克隆抗體
-
貨號:CSB-PA014187
-
規格:¥1100
-
圖片:
-
The image on the left is immunohistochemistry of paraffin-embedded Human cervical cancer tissue using CSB-PA014187(PPIA Antibody) at dilution 1/35, on the right is treated with fusion protein. (Original magnification: ×200)
-
Gel: 12%SDS-PAGE, Lysate: 40 μg, Lane 1-7: PC3 cells, Raji cells, NIH/3T3 cells, K562 cells, hela cells, hepg2 cells, Jurkat cells, Primary antibody: CSB-PA014187(PPIA Antibody) at dilution 1/400, Secondary antibody: Goat anti rabbit IgG at 1/8000 dilution, Exposure time: 5 seconds
-
-
其他:
產品詳情
-
Uniprot No.:
-
基因名:
-
別名:Cyclophilin A antibody; Cyclophilin antibody; CyclophilinA antibody; Cyclosporin A binding protein antibody; Cyclosporin A-binding protein antibody; CYPA antibody; CYPH antibody; Epididymis secretory sperm binding protein Li 69p antibody; HEL S 69p antibody; MGC117158 antibody; MGC12404 antibody; MGC23397 antibody; Peptidyl prolyl cis trans isomerase A antibody; Peptidyl-prolyl cis-trans isomerase A antibody; Peptidylprolyl isomerase A (cyclophilin A) antibody; Peptidylprolyl isomerase A antibody; PPIA antibody; PPIA protein antibody; PPIA_HUMAN antibody; PPIase A antibody; Rotamase A antibody; RotamaseA antibody; T cell cyclophilin antibody
-
宿主:Rabbit
-
反應種屬:Human,Mouse,Rat
-
免疫原:Fusion protein of Human PPIA
-
免疫原種屬:Homo sapiens (Human)
-
標記方式:Non-conjugated
-
抗體亞型:IgG
-
純化方式:Antigen affinity purification
-
濃度:It differs from different batches. Please contact us to confirm it.
-
保存緩沖液:-20°C, pH7.4 PBS, 0.05% NaN3, 40% Glycerol
-
產品提供形式:Liquid
-
應用范圍:ELISA,WB,IHC
-
推薦稀釋比:
Application Recommended Dilution ELISA 1:2000-1:5000 WB 1:500-1:2000 IHC 1:40-1:150 -
Protocols:
-
儲存條件:Upon receipt, store at -20°C or -80°C. Avoid repeated freeze.
-
貨期:Basically, we can dispatch the products out in 1-3 working days after receiving your orders. Delivery time maybe differs from different purchasing way or location, please kindly consult your local distributors for specific delivery time.
-
用途:For Research Use Only. Not for use in diagnostic or therapeutic procedures.
相關產品
靶點詳情
-
功能:Catalyzes the cis-trans isomerization of proline imidic peptide bonds in oligopeptides. Exerts a strong chemotactic effect on leukocytes partly through activation of one of its membrane receptors BSG/CD147, initiating a signaling cascade that culminates in MAPK/ERK activation. Activates endothelial cells (ECs) in a proinflammatory manner by stimulating activation of NF-kappa-B and ERK, JNK and p38 MAP-kinases and by inducing expression of adhesion molecules including SELE and VCAM1. Induces apoptosis in ECs by promoting the FOXO1-dependent expression of CCL2 and BCL2L11 which are involved in EC chemotaxis and apoptosis. In response to oxidative stress, initiates proapoptotic and antiapoptotic signaling in ECs via activation of NF-kappa-B and AKT1 and up-regulation of antiapoptotic protein BCL2. Negatively regulates MAP3K5/ASK1 kinase activity, autophosphorylation and oxidative stress-induced apoptosis mediated by MAP3K5/ASK1. Necessary for the assembly of TARDBP in heterogeneous nuclear ribonucleoprotein (hnRNP) complexes and regulates TARDBP binding to RNA UG repeats and TARDBP-dependent expression of HDAC6, ATG7 and VCP which are involved in clearance of protein aggregates. Plays an important role in platelet activation and aggregation. Regulates calcium mobilization and integrin ITGA2B:ITGB3 bidirectional signaling via increased ROS production as well as by facilitating the interaction between integrin and the cell cytoskeleton. Binds heparan sulfate glycosaminoglycans. Inhibits replication of influenza A virus (IAV). Inhibits ITCH/AIP4-mediated ubiquitination of matrix protein 1 (M1) of IAV by impairing the interaction of ITCH/AIP4 with M1, followed by the suppression of the nuclear export of M1, and finally reduction of the replication of IAV.; (Microbial infection) May act as a mediator between human SARS coronavirus nucleoprotein and BSG/CD147 in the process of invasion of host cells by the virus.; (Microbial infection) Stimulates RNA-binding ability of HCV NS5A in a peptidyl-prolyl cis-trans isomerase activity-dependent manner.
-
基因功能參考文獻:
- Molecular structure of cyclophilin A in complex with alispovir has been presented. PMID: 30198892
- Cyclophilin A is required for HIV-1 Tat palmitoylation . PMID: 29884859
- These results suggested that the CyPA located on SV-HUC-1 cell membranes may be the potential receptor of Mycoplasma genitalium adhesion protein (MgPa), which could provide an experimental basis for elucidating the function of MgPa and the possible pathogenic mechanism of M. genitalium. PMID: 29551599
- increased serum cyclophilin A concentrations could reflect trauma severity and unfavorable outcome after head trauma, substantializing cyclophilin A as a potential biomarker for prognostic prediction of TBI PMID: 29885319
- Here, the binding site of AIF(Delta1-121) and AIF(370-394) on CypA has been mapped by NMR spectroscopy and biochemical studies, and a molecular model of the complex has been proposed. The authors show that AIF(370-394) interacts with CypA on the same surface recognized by AIF(Delta1-121) protein and that the region is very close to the CypA catalytic pocket. PMID: 28442737
- CyPA was significantly increased in convalescent COPD patients and further elevated in COPD patients with acute exacerbation. PMID: 29403273
- CypA expression was not an independent prognostic factor, but correlated with poor prognosis of lung adenocarcinoma PMID: 29027312
- Extracellular cyclophilin A augments platelet-dependent thrombosis and thromboinflammation. PMID: 28981554
- the increased expression of CyPA in ectopic endometrial tissue is associated with endometrioma recurrences and vascularity. PMID: 29081463
- Taken together, these findings reveal an essential role of CypA in boosting RIG-I-mediated antiviral immune responses by controlling the ubiquitination of RIG-I and MAVS. PMID: 28594325
- Data show that cyclophilin A (CypA) is up-regulated in oral squamous cell carcinoma (OSCC) arising from oral submucous fibrosis (OSF). PMID: 27533088
- K308 of NS5A is indispensable for both RNA and NS5B binding, whereas W316 is essential for protein-protein interactions with CypA and NS5B. PMID: 27676132
- PPIA is differentially expressed in lesional biopsy specimens from patients with atopic eczema relative to normal skin PMID: 28479159
- inosine-5'-monophosphate dehydrogenase 2 (IMPDH2) is an intracellular target of the PPIA-Sanglifehrin A binary complex. PMID: 28076787
- these data suggest that CypA-NS4B interaction regulates Yellow fever virus (YFV )replication. Finally, we present the first evidence that YFV inhibition may depend on NS4B-CypA interaction. PMID: 28317380
- This report reviews the literature related to the mechanism of CypA-dependent cytokine secretion and discusses this factor as a possible therapeutic target in inflammatory diseases. PMID: 28729360
- Networks of dynamic allostery regulate cyclophilin A function. PMID: 28089447
- Results show that CypA is overexpressed in human hepatocellular carcinoma (HCC) and is associated with TNM stage and suggest that CypA may be involved in the development and progression of HCC. PMID: 28739738
- Plasma CyPA levels can be used to predict all-cause death, rehospitalization, and coronary revascularization in patients with coronary artery disease. PMID: 28153875
- data suggest that rs6850 G SNP enhances HIV-1 replication through upregulation of CypA expression following HIV-1 infection PMID: 27088296
- These results demonstrate that SUN2 is required for the optimal activation and proliferation of primary CD4 T cells and suggest that the disruption of these processes explains the contribution of endogenous SUN2 to HIV infection in primary lymphocytes and show that CypA is not required for the decreased infection observed in SUN2-silenced cells. PMID: 28077629
- The critical roles of Cyclophilin A in mediating or inhibiting viral infections. [review] PMID: 27033630
- Overexpression of CYPA is associated with colorectal cancer. PMID: 27468721
- PPIA may play a pivotal role in hepatocellular carcinoma (HCC) by regulating cell growth and could serve as a novel marker and therapeutic molecular target for HCC patients. PMID: 27397650
- found to be coupled and temporally dispersed, ranging over 4 to 5 orders of magnitude. Finally, using network centrality measures we demonstrate the changes in the communication network, connectivity, and influence of CypA residues upon substrate binding, mutation, and during catalysis. PMID: 27071107
- Enhanced platelet-bound CyPA is associated with hypertension and hypercholesterolemia in stable coronary artery disease patients. In patients with acute myocardial infarction platelet-bound CyPA is significantly decreased. PMID: 26084004
- results indicate that the PPIA SNP rs6850: A > G is associated with increased risk for elevated plasma levels of cyclophilin A and coronary artery disease in patients with and without type 2 diabetes PMID: 26702934
- the states of phosphorylation of Cyp A by Akt can influence the progress of the cell cycle in multiple myeloma. PMID: 26833980
- review of PPIA polymorphisms and what is known about their impact on the replication cycle and course of disease for different viral infections PMID: 26281011
- The present knowledge on the role of cyclophilin A during coronavirus replication is summarized (Review) PMID: 26318518
- CsA and FK506 might interfere with selected effector T cell functions via a CrkII-, but not CrkI-dependent mechanisms. PMID: 26792730
- Extracellular CyPA activates platelets via cluster of differentiation 147-mediated phosphoinositid-3-kinase/Akt-signaling, leading to enhanced adhesion and thrombus formation independently of intracellular CyPA. PMID: 25550208
- Overexpression of CypA/WT protected the cells against cisplatin or H2O2-induced oxidative damage, however, the CypA/P16S mutant had no effect. These findings suggested that CypA exhibits a protective antioxidant effect PMID: 25738284
- The poor prognosis of esophageal cancer patients was associated with high expression of CypA. PMID: 25420107
- These results indicate a special function mode for CypA of playing more important roles in the early stage of gastric tumorigenesis. PMID: 26008617
- Cyclophilin A regulates HIV-1 replication kinetics and infectivity, modulates sensitivity to host restriction factors, and cooperates in the transit of the pre-integration complex into the nucleus of infected cells. PMID: 25445708
- The frequency of immunihistochemistry detected cyclophilin A protein expression was found to be equal in tumor of both histotypes. PMID: 24272759
- Cyclophilin A regulates JNK/p38-MAPK signaling through its physical interaction with ASK1. PMID: 26095851
- Decrease in plasma cyclophilin A concentration at 1 month after myocardial infarction predicts better left ventricular performance and synchronicity at 6 months. PMID: 25552928
- review of the role of cyclophilin A and CD147 in kidney diseases and potential implications for treatment of kidney diseases PMID: 25580061
- These findings suggest that eCyPA-CD147 signaling promotes the bone marrow homing of B cell malignancies and offer a compelling rationale for exploring this axis as a therapeutic target for these malignancies. PMID: 26005854
- the results indicated that the combination of ENO1 and CYPA can serve as a potential molecular marker for the early detection of NPC. PMID: 24998431
- CypA is secreted from CCA cells and enhances cell proliferation in an autocrine/paracrine manner, at least via direct binding with CD147, which may activate the ERK1/2 and p38 MAPK signaling pathways. PMID: 25296734
- The extracellular portion of cyclophilin A probably plays an important role in human diseases associated with acute or chronic inflammation. PMID: 24713575
- The present data demonstrate that immunophilins regulate CrkII, but not CrkI activity in T cells and suggest that CsA and FK506 inhibit selected effector T cell functions via a CrkII-dependent mechanism. PMID: 25225668
- These results suggested that,CypA, a gene downstream of HIF-1alpha, could promote the development of PDAC. PMID: 24662981
- Cyclophilin A catalyzes proline isomerization by an electrostatic handle mechanism. PMID: 24982184
- These data demonstrate that, while CypA promotes reverse transcription under all conditions tested here, its effect on HIV-1 infectivity correlates more closely with effects on nuclear entry of the viral cDNA. PMID: 24479545
- Inhibition of the AIF/CypA complex protects against intrinsic death pathways induced by oxidative stress. PMID: 24434516
- Patients with type 2 diabetes have higher circulating levels of cyclophilin A than the normal population. PMID: 24502618
顯示更多
收起更多
-
亞細胞定位:Cytoplasm. Secreted. Nucleus.
-
蛋白家族:Cyclophilin-type PPIase family, PPIase A subfamily
-
數據庫鏈接:
Most popular with customers
-
-
Phospho-YAP1 (S127) Recombinant Monoclonal Antibody
Applications: ELISA, WB, IHC
Species Reactivity: Human
-
-
-
-
-
-
VCP Recombinant Monoclonal Antibody
Applications: ELISA, WB, IHC, IF, IP
Species Reactivity: Human, Rat